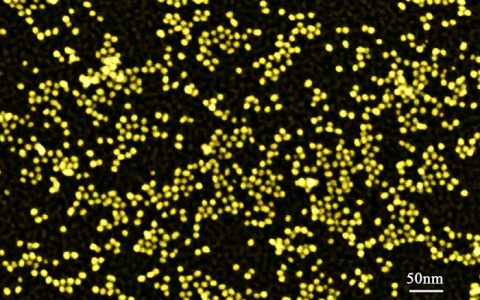

1、Nature: 通过胶体键合杂化和吸引作用实现微胶囊的自组装 图1 自组装单层微胶囊颗粒的SEM/TEM图 具有定向交换作用的颗粒是新型功能材料最具有潜力的...

引语: 众所周知,纳米粒子经常表现出与常见大尺度物质不同的性质,应用领域也大相径庭。比如金纳米粒子可以催化化学反应,而普通金不能催化。半导体的纳米粒子仅通过尺寸...

【背景简介】 发光二极管(LEDs)、有机LEDs、显示器、触摸屏、太阳能电池、智能窗等,当今这些已有的新兴设备都需要具有高透光率(T)和较低薄膜电阻(Rs)的...


XAS以其亚原子分辨率、超高电子结构敏感度,在分析材料电子轨道、配位环境中不可或缺。(什么,你对千纸鹤的话还有怀疑)那我们看看下面千纸鹤收集的XAS的一组数据。...


新闻简介: 未来信息技术的发展很大程度上取决于我们控制材料微观结构的技术。在微电子学和自旋电子学中,研究三维结构制造的模式,能够帮助加快信息传递的效率,增加功能...

材料牛注:随着对纳米尺度的理解,中国研究者团队研发了一种可视化的基于原位透射电镜技术,该技术直接将原子尺度的结构和物化性能联系起来,可提供新颖而强大的功能。 在...

1、Nature Communications:C-MoS2异质结构界面应变影响 图1 界面的SEM/TEM图及拉曼光谱和EDX能谱图 二维(2D)材料由于电荷...


自从19世纪白炽灯被发明以来,发光二极管是最重要的进展之一。然而白炽灯在红外波段有很大的能量热耗散,典型的LEDs也仅仅覆盖可见光波段。对于大多数LEDs都是基...

国内周报第47期摘要:中科院福建物质结构研究所提出将金属有机骨架整合到电化学介电薄膜的新方法;燕山大学首次设计并合成一种新型抗肿瘤体系;中科院化学所设计出可捕获...


材料牛注:你是否思考过完全失去摩擦的表面会是怎么样的?本文将带你走进各种无摩擦的世界,领略其从高端的军事运用到平常泳衣的魔力之所在。 多少次我们在高中物理课上看...

银纳米团簇具有优良的光学性能以及特殊的重金属敏感性,在荧光标记、生物成像、重金属识别方面都具有很大的应用潜质。然而银团簇的研究中仍旧面临着很多问题和挑战,其中包...

材料牛邀请您阅读五月份计算材料前沿科研成果精选:西安交通大学发现由非线性弹性效应引起的异质外延岛的热力学自限制生长机制;美国西北大学发现π-共轭有机半导体新单元...

1、Science:光子自旋控制多功能共用孔径天线阵列 图1 共享孔径概念的示意图 在雷达应用领域,开发的共享孔径天线阵列是增加光电功能的一种有效方法,它是在共...


材料牛注:美国能源部阿贡国家实验室的研究者们通过使用二氧化钒纳米材料,研发出具有单一窗格的窗户,从而提高了能源的利用效率。 美国能源部阿贡国家实验室的研究者们使...
